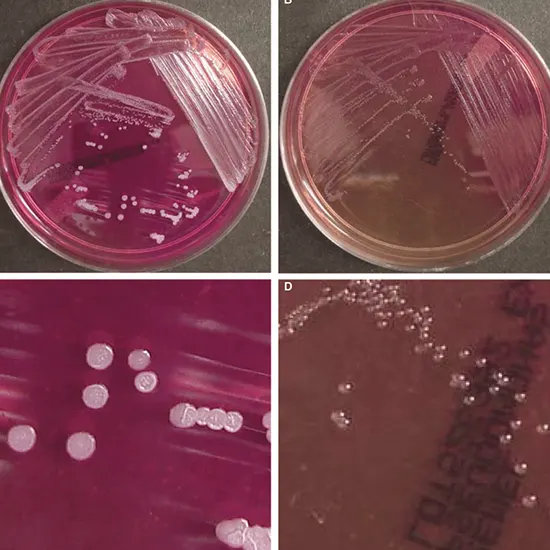

Burkholderia malleus is a gram-negative bacterium that is the causative agent of the disorder glanders in horses, donkeys, and mules. It can additionally infect different mammals, together with humans.
Burkholderia malleus is a gram-negative bacterium that is the causative agent of the disorder glanders in horses, donkeys, and mules. It can additionally infect different mammals, together with humans.
The bacterium is extraordinarily infectious and can unfold without difficulty through contaminated soil, water, or direct contact with contaminated animals or materials.
Burkholderia mallei are viewed as a possible bioterrorism agent due to their capability to be weaponized and their excessive mortality charge if left untreated. The sickness can be dealt with antibiotics, however, early detection and the spot remedy are indispensable for a profitable outcome.
What are Burkholderia mallei?
Burkholderia malleus is a gram-negative bacterium that causes the disorder of glanders. It notably influences horses, donkeys, and mules, however, can additionally infect different mammals, together with humans.
The bacterium is especially infectious and can unfold through contact with contaminated animals, contaminated soil or water, or inhalation of aerosolized bacteria. Glanders can cause extreme respiratory distress, and fever, and can even be deadly if left untreated.
Burkholderia mallei are categorized as achievable bioterrorism agents due to their capability to be weaponized and the lack of fine vaccines or treatments.
Variants of Burkholderia mallei
There are only one recognised species of Burkholderia mallei
However, there are two diagnosed subspecies of Burkholderia mallei, primarily based on their geographic distribution and genetic differences:
Burkholderia mallei subsp. mallei
This subspecies is located by and large in Africa, Asia, and the Middle East and is accountable for most instances of glanders worldwide.
Burkholderia mallei subsp. holarctica
This subspecies is determined in most cases in Europe and Asia and is accountable for most instances of glanders in Eurasia.
Both subspecies of Burkholderia mallei can motivate glanders in people and animals, though their scientific manifestations can also fluctuate slightly.
Explore the Epidemiology of Burkholderia mallei
Burkholderia mallei are principally determined in areas where glanders are endemic, such as components of Africa, Asia, the Middle East, and South America.
The bacterium can infect a large variety of mammals, consisting of horses, donkeys, mules, camels, dogs, and cats, as properly as humans.
Glanders is a disorder in humans, with solely a few instances stated every year. However, the hazard of transmission is elevated in people who work with contaminated animals, such as veterinarians, animal handlers, and laboratory workers.
Glanders can be transmitted through direct contact with contaminated animals or materials, such as contaminated soil or water.
In some cases, the disorder can additionally be transmitted thru inhalation of aerosolized bacteria, which can appear throughout laboratory work or if the bacterium is used as a bioterrorism agent.
The incubation length of glanders degrees from several days to various weeks, and the ailment can have a persistent or acute course, relying on the mode of transmission and the immune repute of the contaminated individual.
Effective surveillance and managed measures, such as quarantine, testing, and therapy of contaminated animals, are imperative for stopping the unfolding of glanders in each animal and human.
Early detection and instant remedy with antibiotics are additionally necessary for making sure of a profitable effect in human instances of glanders.
Let's Learn About the Pathophysiology of Burkholderia mallei
Burkholderia malleus is an intracellular bacterium that can infect a large variety of cells, along with macrophages and neutrophils.
The bacterium can stay clear of the immune gadget by way of inhibiting the manufacturing of reactive oxygen species and via modulating the host immune response.
Once internal to the host cell, the bacterium can replicate and unfold to different cells, mainly to the formation of abscesses and tissue damage.
In horses and different animals, Burkholderia mallei chiefly infect the respiratory system, inflicting coughing, fever, and nasal discharge.
The bacterium can additionally infect different organs, such as the skin, liver, and spleen, mainly to the formation of nodules or abscesses.
In humans, the disorder can have quite a few scientific manifestations, which include acute or continual respiratory disease, pores and skin lesions, and septicemia.
Inhalation of aerosolized microorganisms can lead to the improvement of extreme respiratory distress, which can grow to pneumonia and sepsis if left untreated.
Cutaneous glanders, which happen when the bacterium enters the physique via a smash in the skin, can lead to the formation of painful nodules and ulcers.
The severity of glanders relies upon the mode of transmission and the immune repute of the contaminated individual.
In folks with a weakened immune system, such as those with HIV or malnutrition, the disorder can grow unexpectedly and lead to an excessive mortality rate.
Signs and Symptoms of Burkholderia mallei Infections
The symptoms and signs of Burkholderia mallei contamination can fluctuate relying on the mode of transmission, the website online infection, and the immune popularity of the contaminated individual.
In horses and different animals, the most frequent symptoms of glanders include:
- Coughing
- Problem in breathing
- Nasal discharge
- Swelling of the lymph nodes in the head and neck
- Fever
- Depression
- Skin nodules
- Abscesses
In humans, the signs of glanders can vary from slight to extreme and can exist in several distinctive ways:
- Acute or continual respiratory disease, with signs such as coughing, chest pain, and problem breathing
- Skin lesions, along with nodules, pustules, and ulcers
- Fever, chills, and fatigue
- Septicemia, which can lead to septic shock and more than one organ failure
- Glanders can be hard to diagnose, as the signs can be comparable to those of different respiratory or pores and skin infections.
It is necessary to search for clinical interest if you have been uncovered to Burkholderia mallei or if you improve any signs of glanders, particularly if you work with animals or in a laboratory setting. Early analysis and cure are essential for a profitable outcome.
Diagnostic Methods for the Detection of Burkholderia Mallei
The prognosis of Burkholderia mallei contamination can be challenging, as the bacterium is a workable bioterrorism agent and requires specialised laboratory amenities for coping with and testing.
Several diagnostic assessments are available, including:
Culture
Burkholderia mallei can be cultured Blood Culture from samples of blood, sputum, or different physique fluids. However, lifestyle can take several days to produce effects and requires specialized laboratory facilities.
Serology
Blood assessments can notice antibodies to Burkholderia mallei, indicating past or contemporary infection. However, serology checks can produce false-positive or false-negative consequences and are no longer continually reliable.
Polymerase chain response (PCR)
PCR can notice the genetic cloth of Burkholderia mallei in samples of blood, sputum, or different physique fluids. PCR can supply speedy and sensitive detection of the bacterium, however, it requires specialized laboratory amenities and expertise.
Imaging
Chest X-rays or CT scans may additionally exhibit symptoms of pneumonia or lung abscesses in humans with respiratory glanders.
It is essential to be looking for scientific interest if you have been uncovered to Burkholderia mallei or if you enhance any signs and symptoms of Ultrasound glanders, in particular, if you work with animals or in a laboratory setting. Early analysis and cure are necessary for a profitable outcome.
Various Possible Complications of Burkholderia mallei
Complications of Burkholderia mallei contamination can rely on the mode of transmission, the web page of infection, and the immune reputation of the contaminated individual.
In animals, untreated glanders can lead to persistent infection, weight loss, and death. In humans, glanders can be an extreme and life-threatening disease, specifically in men and women with a weakened immune system.
Complications of glanders can include:
Respiratory failure
Inhalation of aerosolized microorganisms can lead to extreme respiratory misery and pneumonia, which can grow to respiratory failure if left untreated.
Sepsis
Glanders can lead to septicemia, which can cause septic shock, more than one organ failure, and death.
Skin and smooth tissue infections
Cutaneous glanders can lead to the formation of nodules, ulcers, and abscesses, which can grow to be contaminated and motivate secondary pores and skin and gentle tissue infections.
Chronic infection
In some cases, glanders can end up with a persistent infection, mainly due to ongoing signs and symptoms and tissue damage.
Spread to different organs
Burkholderia mallei can unfold to different organs, such as the liver, spleen, and lymph nodes, mainly to organ harm and dysfunction.
Early prognosis and instantaneous therapy with antibiotics are fundamental for stopping issues of glanders. It is necessary to try to find clinical interest if you have been exposed to Burkholderia mallei MRI Pelvis or if you increase any signs and symptoms of glanders, in particular, if you work with animals or in a laboratory setting.
Treatment Options for Burkholderia mallei
Treatment of Burkholderia mallei contamination includes an aggregate of antibiotics and supportive care.
Antibiotics that have been used efficiently to deal with glanders include:
- Ceftazidime
- Doxycycline
- Trimethoprim-sulfamethoxazole
- Amoxicillin-clavulanic
- Acid Imipenem-cilastatin
The desire for antibiotics and the length of therapy rely on the severity of the infection, the mode of transmission, and the immune fame of the contaminated individual.
In Conclusion, Burkholderia mallei is an especially infectious bacterium that can target glanders in animals and humans, and early diagnosis, treatment, and prevention measures are indispensable to controlling its spread.
Stay vigilant against Burkholderia Mallei : protecting ourselves and our animals!









